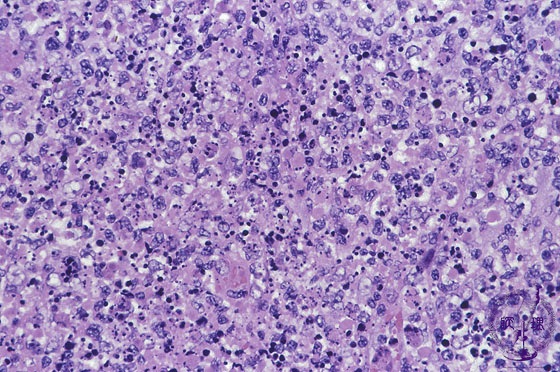

- 2.Lymph node
- (1)Histiocytic necrotizing lymphadenitis
Microscopic image (H&E high power view): There are numerous apoptotic bodies and nuclear debris admixed with macrophages and large transformed lymphocytes. However, in comparison with the previous image a neutrophil, eosinophil or plasma cell inflammatory response is lacking.
Click the image to see the enlarged image.









